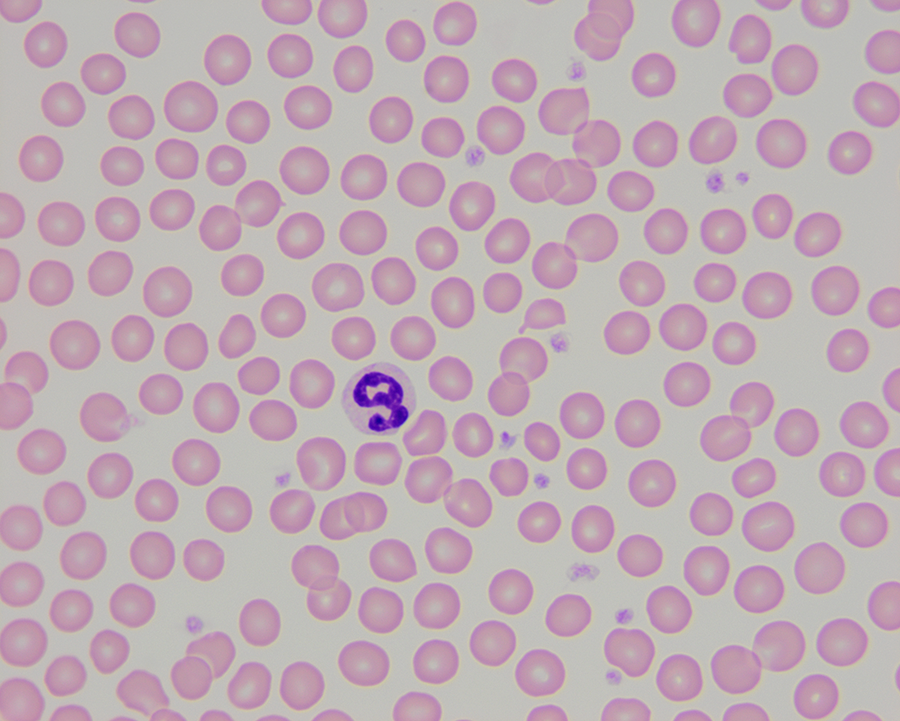
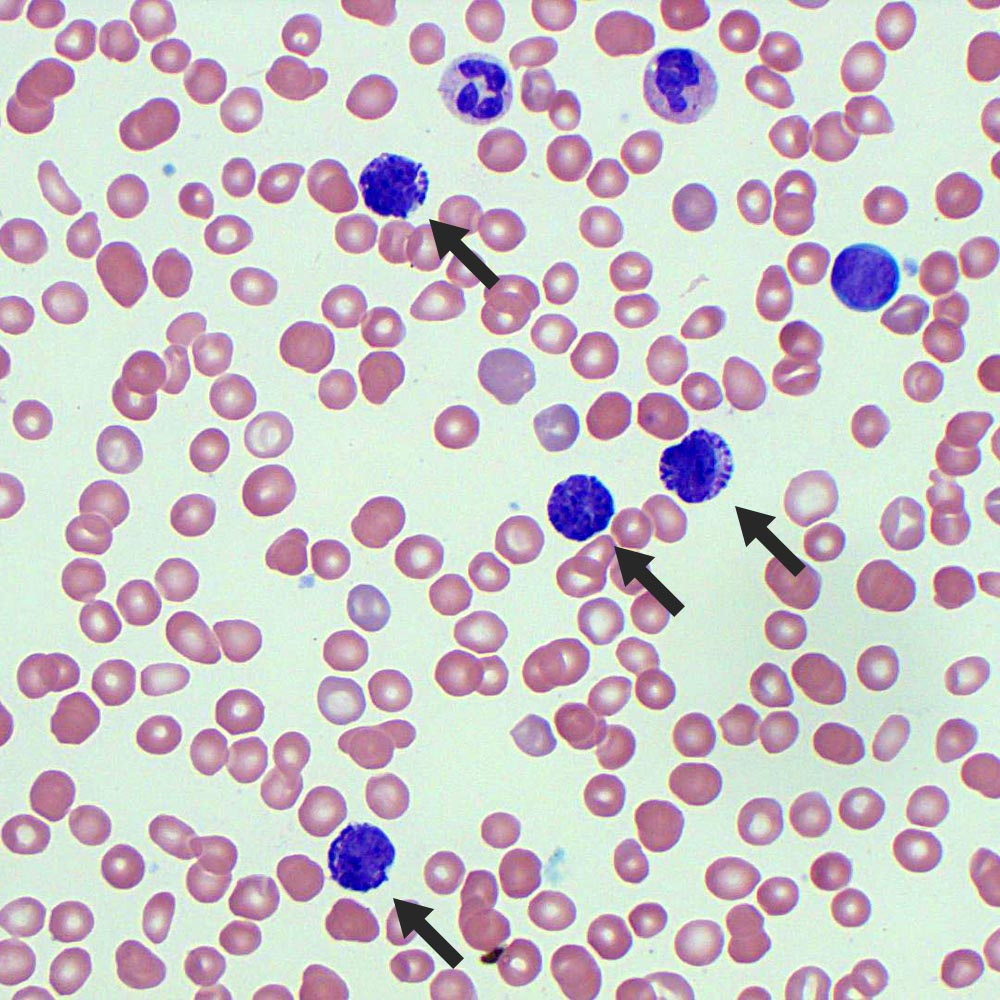

Blood and Bone Marrow
1/33
Earn XP
Description and Tags
LSU SVM
Name | Mastery | Learn | Test | Matching | Spaced |
|---|
No study sessions yet.
34 Terms
What is the function of an erythrocyte?
oxygen-carrying red blood cells
What are the characteristics of erythocytes?
eosinophilic anucleated biconcave disk
When does the central pallor increase in size?
when patient is anemic due to reduced amount of hemoglobin
What determines the function of the cell?
specific granules
What is the function of neutrophils?
first responder to bacterial infection, can move through tissue to kill bacteria
What is the function of eosinophil?
major function is to kill parasites but can also assist with allergic reactions
What is the function of basophils?
contains substance that facilitate hypersensitivity and anaphylaxis reactions
What is the function of lymphocytes?
responds to viruses and some types may mature into cells that secrete antibodies
What is the function of monocytes?
phagocytic, cleans up cells and tissue debris after an infection or tissue damage
What is the function of platelets?
stop bleeding when injured, coagulation
What is another name for platelets?
thrombocytes
What regulates hematopoiesis?
megakaryocytes
What is hematopoiesis?
formation of blood cells
What is the characteristic of the nucleus of neutrophils?
multi-lobed
What is the equivalent to neutrophils in non-mammalian blood?
heterophils
What cells are similar to mast cells?
basophils
What are the three types of lymphocytes?
T, B, and natural killer (NK) cells
What makes platelets different in non-mammalian blood?
full cells not fragments
As an animal ages, what kind of marrow replaces the other?
red marrow is replaced by yellow marrow
What is the function of macrophages?
antigen presenting cells
What is erythropoiesis?
development of erythocytes
What is leukopoiesis?
development of leukocytes
What is thrombopoiesis?
development of platelets
When is hematopoiesis initiated?
early embryonic life
What are the largest cells?
monocytes
What are the most common cells?
lymphocytes
What are the granulocytes?
neutrophils, eosinophils, and basophils
What are the agranulocytes?
lymphocytes and monocytes
What cell is demonstrated in the image?
neutrophil

What cell is demonstrated in the image?
eosinophil
What cell is demonstrated in the image?
basophil

What cell is demonstrated in the image?
lymphocytes

What cell is demonstrated in the image?
monocytes

Identify the marrow to the left.
yellow